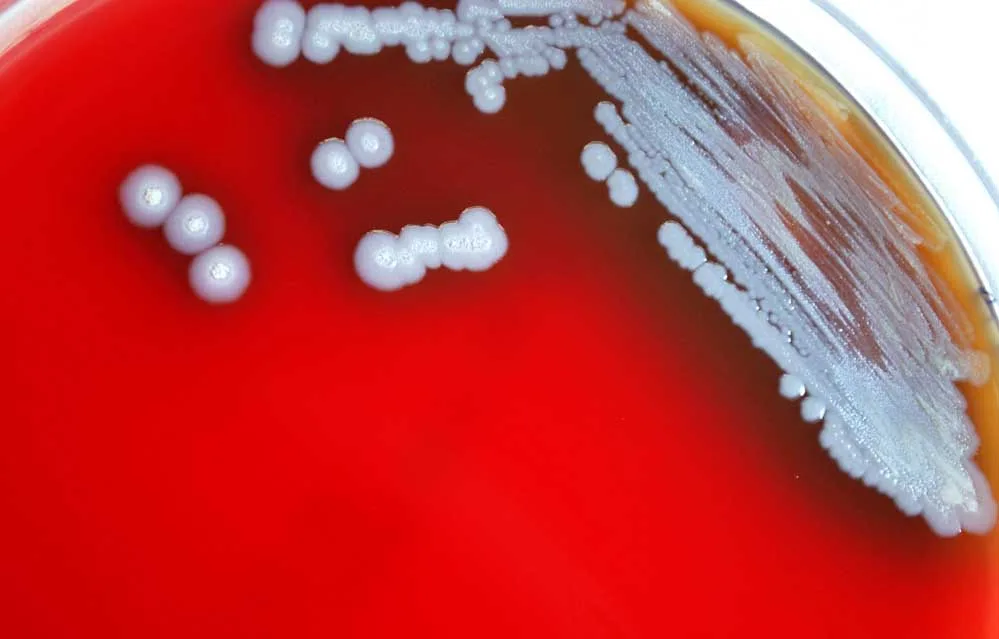

मिट्टी और पानी से फैलने वाला मेलियोइडोसिस बना चिंता का कारण, MP में अलर्ट, 40% मरीजों की मौत
भोपाल
मध्य प्रदेश में नई बीमारी की दस्तक से स्वास्थ्य विभाग में हड़कंप मचा हुआ है. इसको लेकर पूरे प्रदेश में अलर्ट जारी कर दिया गया है. सीएम मोहन यादव भी इसको लेकर काफी एक्शन में नजर आ रहे हैं. उन्होंने मेलिओइडोसिस बीमारी की रिसर्च पर संज्ञान लेते हुए इसे रोकथाम के निर्देश दिए हैं. वहीं सीएम मोहन यादव ने स्वास्थ्य विभाग के प्रमुख सचिव और कृषि प्रमुख सचिव को संयुक्त रूप से मेलिओइडोसिस मरीजों की जांच, इलाज और रोकथाम के लिए स्वास्थ्य सिविर लगाने के लिए निर्देश दिए हैं. मध्यप्रदेश में संक्रामक बीमारी मेलियोइडोसिस को लेकर नेशनल हेल्थ मिशन (NHM) ने अलर्ट जारी किया है। यह बीमारी मिट्टी और पानी में पाए जाने वाले बर्कहोल्डेरिया स्यूडोमेलाई नामक बैक्टीरिया से फैलती है। बरसात और नमी के मौसम में इसके संक्रमण की संभावना और बढ़ रही।
मेलियोइडोसिस को विश्व स्वास्थ्य संगठन (WHO) ने उभरती हुई उपेक्षित बीमारियों की सूची में शामिल किया है। दक्षिण-पूर्व एशिया और ऑस्ट्रेलिया के बाद भारत के मध्यप्रदेश, छत्तीसगढ़ और ओडिशा राज्य, इसके नए हॉटस्पॉट बनते दिख रहे हैं।
एम्स भोपाल की बीते मंगलवार को आई रिपोर्ट के अनुसार, पिछले छह सालों में प्रदेश के 20 से अधिक जिलों से 130 से ज्यादा केस सामने आ चुके हैं। यह बीमारी अब स्थानिक (एंडेमिक) रूप ले चुकी है। रिपोर्ट में यह भी सामने आया कि मेलियोइडोसिस से पीड़ित हर 10 मरीजों में 4 की मौत हो रही है। चौंकाने वाली बात यह है कि इसके लक्षण अक्सर टीबी जैसे लगते हैं, जिससे मरीजों को गलत इलाज मिलता है और संक्रमण पूरे शरीर में फैल जाता है।
20 जिलों में आ चुके केस एम्स की रिपोर्ट बताती है कि पिछले 6 सालों में प्रदेश के 20 से अधिक जिलों से 130 से ज्यादा केस सामने आ चुके हैं। विशेषज्ञों का कहना है कि यह बीमारी अब प्रदेश में स्थानिक (एंडेमिक) रूप ले चुकी है। एम्स ने डॉक्टरों और आम जनता दोनों से अपील की है कि लंबे समय तक ठीक न होने वाले बुखार और टीबी जैसे लक्षणों को हल्के में न लें।
14 नए केस और WHO की चेतावनी एम्स भोपाल ने 2023 से अब तक चार विशेष प्रशिक्षण आयोजित किए हैं, जिनमें 50 से अधिक चिकित्सक और माइक्रोबायोलॉजिस्ट प्रशिक्षित हुए। हाल ही में 14 नए केस जीएमसी भोपाल, बीएमएचआरसी, जेके हॉस्पिटल, सागर और इंदौर से रिपोर्ट हुए। विशेषज्ञों का कहना है कि पहचान की क्षमता बढ़ने से केस तेजी से सामने आ रहे हैं।
बीमारी के लक्षण
- अचानक तेज बुखार और सेप्सिस (खून का संक्रमण)
- कम्युनिटी-एक्वायर्ड न्यूमोनिया (फेफड़ों का संक्रमण)
- त्वचा और मुलायम ऊतक (Soft Tissue) में संक्रमण
- लिवर, प्लीहा, प्रोस्टेट या पैरोटिड ग्रंथि में गहरे फोड़े (Abscess)
- हड्डियों और जोड़ों का संक्रमण (ऑस्टियोमायलाइटिस, सेप्टिक आर्थ्राइटिस)
- लंबे समय में यह टीबी जैसा दिख सकता है — वजन घटना, खांसी, बुखार और फेफड़ों में इन्फेक्शन
एम्स की सलाह यदि किसी को 2–3 हफ्तों से अधिक बुखार है, एंटी-टीबी दवा से लाभ नहीं हो रहा या बार-बार फोड़े बन रहे हैं, तो तुरंत विशेषज्ञ से मेलियोइडोसिस की जांच करवाएं। यही सावधानी जीवन बचा सकती है।
इन जांच से होगी रोग की पुष्टि
खून, पस, थूक, यूरिन या सीएसएफ (रीढ़ के तरल) का सैंपल
ब्लड एगर, मैककॉनकी या ऐशडाउन मीडियम पर कल्चर टेस्ट
माइक्रोस्कोप में सुरक्षा-पिन जैसे धब्बे (Safety-pin staining)
यह बैक्टीरिया ऑक्सीडेज पॉजिटिव और अमिनोग्लाइकोसाइड्स/पोलिमिक्सिन रेसिस्टेंट होता है
जहां संभव हो, पीसीआर टेस्ट से पुष्टि
एडवाइजरी में दिए बचाव के उपाय
- खेत में काम करते समय जूते-दस्ताने पहनें
- खुले घाव को मिट्टी-पानी से बचाकर रखें
- संदिग्ध लक्षण पर तुरंत जांच
- समय पर एंटीबायोटिक उपचार
- डॉक्टर के बताए कोर्स का पालन
कैसे फैलता है ये बैक्टीरिया?
मेलियोइडोसिस एक बैक्टीरियल संक्रमण है, जो इंसानों और जानवरों दोनों को प्रभावित करता है. खास तौर से यह दूषित मिट्टी, पानी या हवा से शरीर में प्रवेश करता है. खासतौर से अगर त्वचा पर घाव है तो यह बैक्टीरिया जल्दी शिकार बना सकता है, इसके अलावा दूषित खाने या पानी की वजह से भी ये शरीर में प्रवेश कर जाता है. ये किसी व्यक्ति से व्यक्ति में नहीं फैलता. खासतौर से बारिश, तूफान या बाढ़ के बाद इसके मामले ज्यादा बढ़ जाते हैं क्योंकि यह बैक्टीरिया मिट्टी की सतह पर आ जाता है. पहले इस बीमारी के मामले कर्नाटक, तमिलनाडु और ओडिशा में ज्यादा सामने आते हैं, मगर अब यह मध्य प्रदेश में तेजी से पैर पसार रही है.
20 जिलों में सामने आए मामले
मेलियोइडोसिस बैक्टीरिया के मामले अब तक मध्य प्रदेश के 20 जिलों में सामने आ चुके हैं. खास तौर से ये ग्रामीण इलाकों में ज्यादा फैल रहा है, अब तक मध्य प्रदेश में इसके 130 मामले सामने आ चुके हैं. AIIMS भोपाल की ओर से हाल ही में इस पर एक रिपोर्ट भी जारी की गई है, इसमें बताया गया है कि इस बीमारी की वजह से हर 10 में से 4 लोगों की मौत हो जाती है. रिपोर्ट में ये भी बताया गया है कि यह बैक्टीरिया पानी, मिट्टी की वजह से फैल रहा है.
टीबी जैसे लक्षण, अनदेखी न करें
एम्स भोपाल की ओर से जारी रिपोर्ट में बताया गया है कि इस बैक्टीरिया के लक्षण टीबी की तरह हैं, हाल ही में इसके 14 नए मामले सामने आए हैं जो मध्य प्रदेश के अलग अलग हॉस्पिटल्स में इलाज करा रहे हैं. एम्स की ओर से जारी रिपोर्ट में कहा गया है कि अगर किसी को टीबी के लक्षण भी नजर आएं तो तुरंत जांच कराएं. रिपोर्ट के मुताबिक हाल ही में एक 45 वर्षीय किसान मेलियोइडोसिस से पीड़ित था, लेकिन वह कई महीने तक टीबी का इलाज ही कराता रहा, जिससे उसकी हालत बिगड़ती रही, बाद में बैक्टीरिया की बात सामने आने के बाद ही उसे बचाया जा सका.
क्या हैं इसके लक्षण, कब आते हैं नजर?
मेलियोइडोसिस का सबसे बड़ा लक्षण बुखार है. बैक्टीरिया के संपर्क में आने से खासी और सीने में दर्द की शिकायत हो सकती है. इसके अलावा शरीर में फोड़े और घाव की समस्या भी हो सकती है. इसके अलावा सिरदर्द, पेट दर्द, मांसपेशियों में दर्द की शिकायत रह सकती है. गंभीर मामलों में निमोनिया, सेप्सिस तथा मौत तक हो सकती है. इसके लक्षण 1 से 3 सप्ताह में दिख सकते हैं, कई बार इसके लक्षण महीनों या सालों बाद भी नजर आ सकते हैं. यह किसी एक अंग को या पूरे शरीर को प्रभावित कर सकती है. एम्स की रिपोर्ट के मुताबिक जिन लोगों को डायबिटीज, लिवर या किडनी की बीमारी पहले से, उन्हें इससे ज्यादा खतरा है. इसके अलावा कैंसर रोगी, कमजोर इम्युन सिस्टम वाले लोगों को भी इससे सावधान रहना चाहिए.
बचाव के लिए क्या करें?
मेलियोइडोसिस एक घातक बीमारी है, 10 से 4 लोगों की इससे मौत हो सकती है. इसलिए लक्षण दिखने पर तुरंत ही इसका इलाज लेना चाहिए. बीमारी के बारे में जानकारी होने के बाद 2 से 8 सप्ताह तक एंटीबायोटिक्स इंजेक्शन लगते हैं, इसके अलावा 3 से 6 माह तक दवा खानी होनी होती है, बस इसका कोर्स करना जरूरी है. इससे बचाव के लिए जरूरी ये है कि अगर घाव है तो मिट्टी और दूषित पानी से दूर रहें, डॉक्टरों को लक्षण बताएं.






